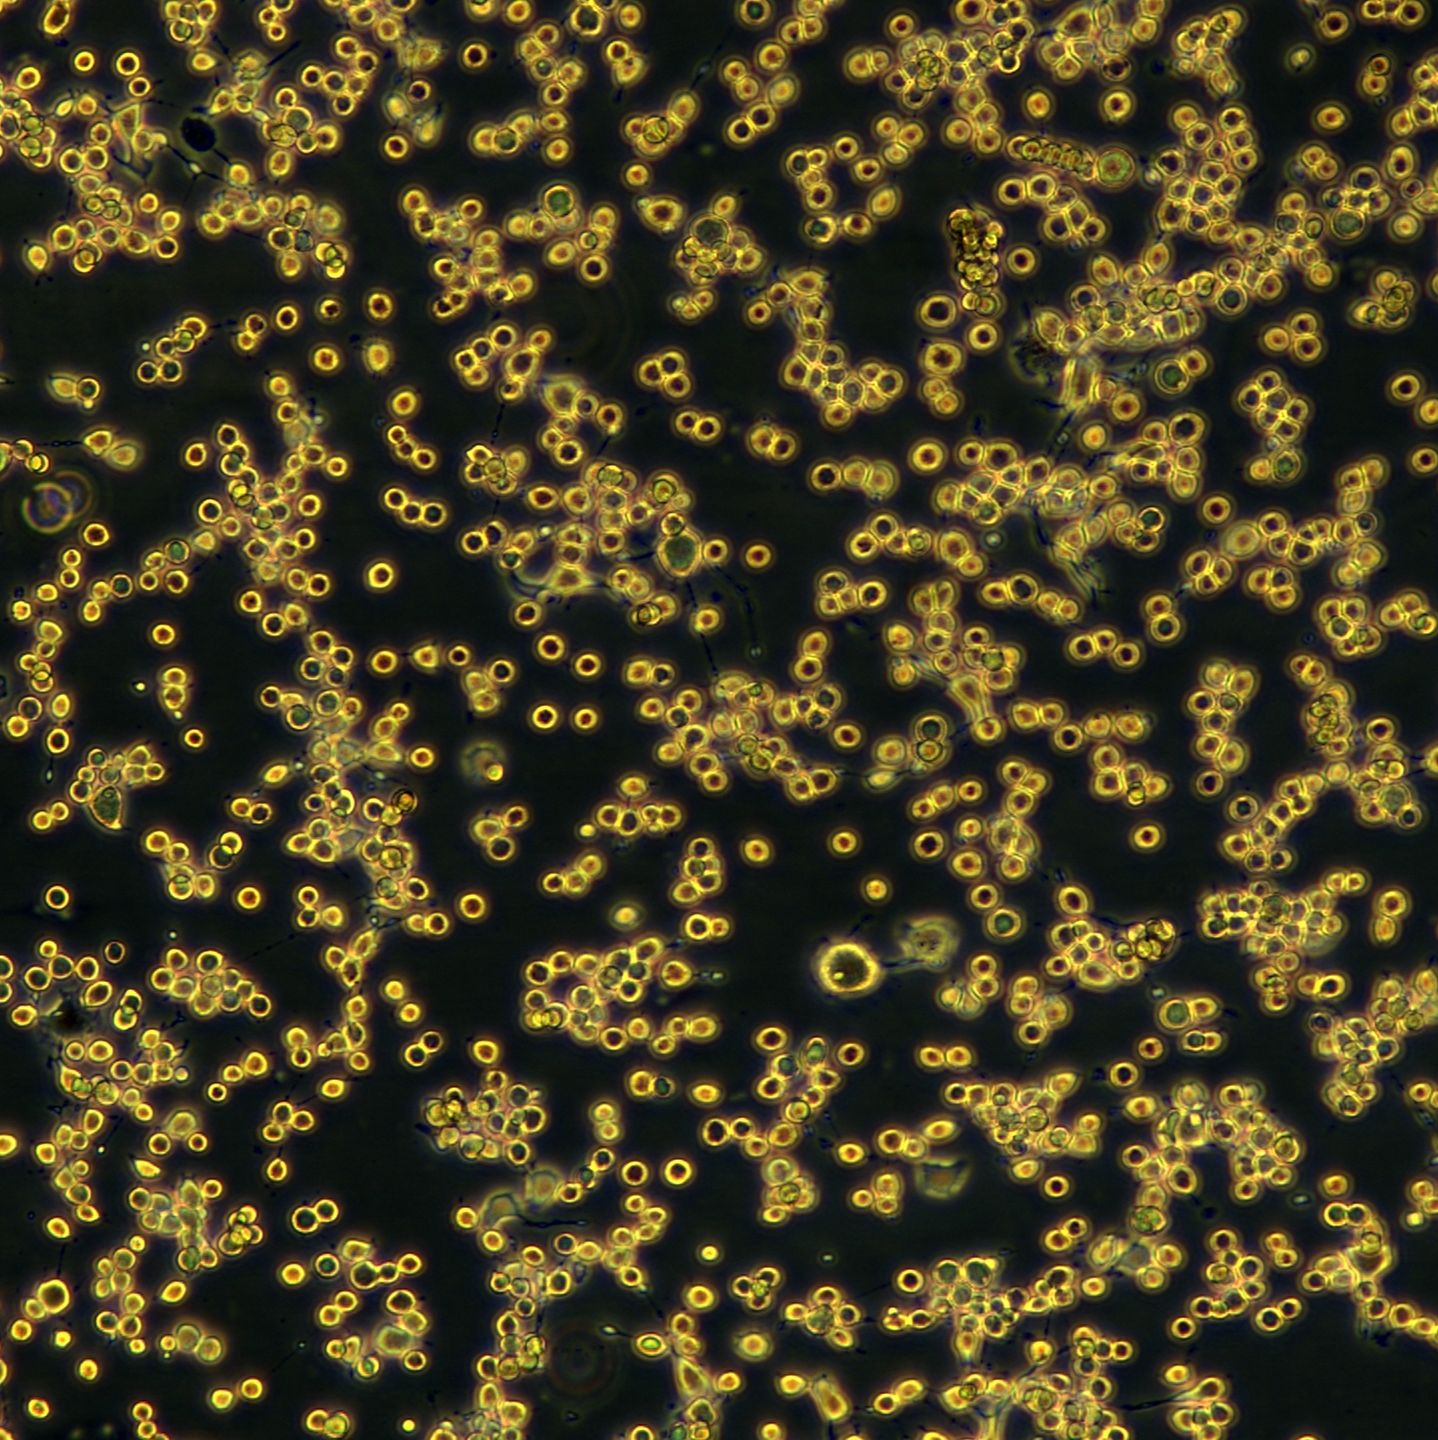
产品封面图
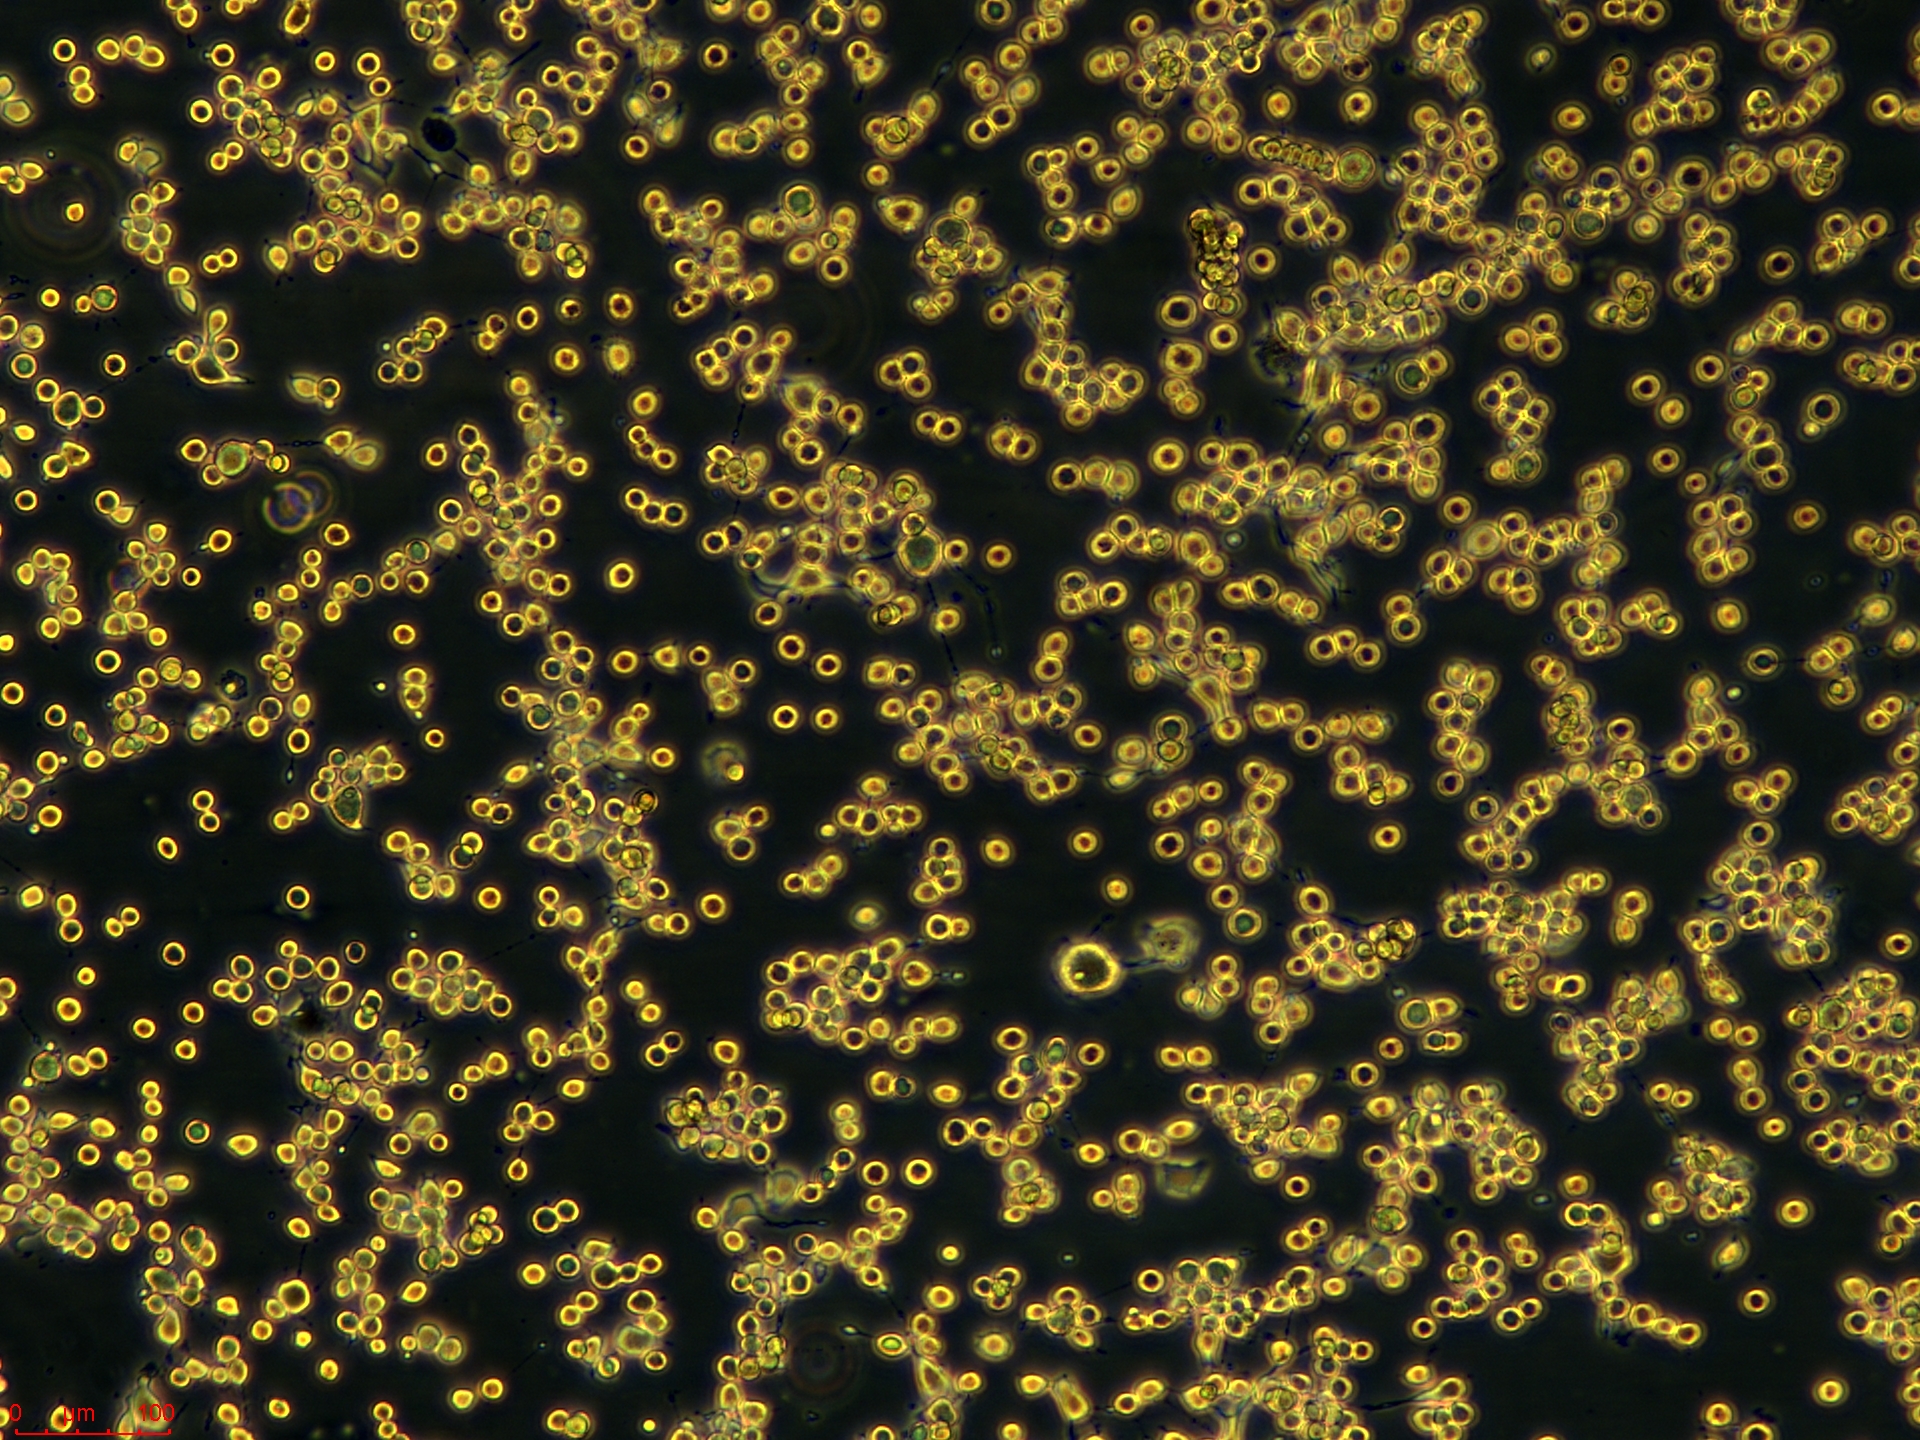
Project_MFC_ch00.jpg

相关产品推荐更多 >
万千商家帮你免费找货
0 人在求购买到急需产品
- 详细信息
- 文献和实验
- 技术资料
- 英文名:
MFC
- 库存:
99
- 相关疾病:
小鼠胃癌(Mouse gastric carcinoma)
- 物种来源:
小鼠(Mus musculus)
- 细胞形态:
表皮细胞(Epithelial)
- 运输方式:
常温或干冰冻存发货 空运、快递
- 生长状态:
贴壁生长(Adherent)
- 规格:
T25/冻存管
| 规格 | T25 |
| 货号 | CTCC-400-0334 |
| 种属 | 小鼠(Mus musculus) |
| 组织来源 | 未知(Unknown) |
| 疾病 | 小鼠胃癌(Mouse gastric carcinoma) |
| 年龄 | 未知(Unknown) |
| 培养体系 | 该细胞系培养所用基本培养基为 RPMI1640 Medium,配置完全培养基时 需加入10%FBS,1% Anti-Anti。 |
| 细胞形态 | 表皮细胞(Epithelial) |
| 生长特性 | 贴壁生长(Adherent)![]() ![]() ![]() |
风险提示:丁香通仅作为第三方平台,为商家信息发布提供平台空间。用户咨询产品时请注意保护个人信息及财产安全,合理判断,谨慎选购商品,商家和用户对交易行为负责。对于医疗器械类产品,请先查证核实企业经营资质和医疗器械产品注册证情况。
文献和实验最终pH7.4±0.2 使用方法: 1、 称取本品52.2g,加入蒸馏水或去离子水1 L,搅拌加热煮沸至完全溶解,冷至50℃左右,倾注平皿,待凝固后备用。 2、 水样抽滤。水样滤完后,再抽气约5秒,关上阀门,取下滤器,用灭菌镊子夹取滤膜边缘部分,移放在MFC培养基上,滤膜截留面向上,滤膜应与培养基完全贴紧,两者间不得留有
实验材料: 1. 细胞来源:8—12天龄的小鼠; 2. 清洗液:不含Ca2+ 和Mg2+ 的1×PBS,添加200000IU/L青霉素、200mg/L链霉素,pH7.4; 3. 消化液:0.3%胶原酶溶液,含4%牛血清白蛋白。用Hanks液配制; 4. DW培养液:DMEM和WAJC404培养液按1:1(V/V)混合,添加100IU/ml青霉素、50µg/ml链霉素; 5. 培养液a:DW培养液,10%胎牛血清; 6. 培养液b:DW培养液,补充胰岛素10
7. MFC — 小鼠胃癌细胞 MFC细胞是由钱书森、高进等于1985年建立;利用源自615小鼠前胃鳞癌移植瘤FC瘤组织,小块法培养得到,已传132代;MFC细胞在615小鼠皮下移植100%成功。 8. SNU601 — 人胃癌细胞 SNU601细胞来自34岁亚洲男性胃印戒细胞腺癌患者,是一种低分化的印戒细胞腺癌细胞。 六、参考文献 [1] 张学庸. 胃癌的基础研究与临床. [2] Correa P. Gastric cancer: overview. Gastroenterol Clin North